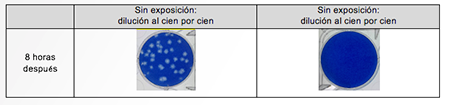
P 1

Ha verificado el efecto inhibitorio de nanoe™ sobre el nuevo coronavirus adherido en un espacio de prueba de 24 m3. Esta es la primera vez en el mundo que se verifica el efecto inhibidor sobre el nuevo coronavirus en un espacio de prueba casi tan grande como en el que vivimos de forma habitual.
nanoe™ es una tecnología que recoge la humedad invisible del aire y le aplica un alto voltaje para producir "radicales hidroxilos contenidos en el agua". Los radicales hidroxilos inhiben el crecimiento de contaminantes como las bacterias y los virus. Se caracterizan por ser fuertemente oxidativos y altamente reactivos, de ahí su corta vida. Contenida en diminutas partículas de agua, la tecnología nanoe™ tiene una larga vida útil y puede extenderse por todo el espacio de una habitación. Tiene un efecto inhibidor tanto de las sustancias transportadas por el aire como de las adheridas.
La mutación del aminoácido en la proteína espícula ha provocado nuevas cepas variantes con diferente infectividad, transmisibilidad y antigenicidad con una mayor capacidad de unirse a las células y una menor a los anticuerpos neutralizantes. En consecuencia, la propagación mundial del nuevo coronavirus no muestra signos de disminuir. Se están realizando investigaciones para identificar las propiedades de la cepa Omicron dominante actual, pero el aumento de las infecciones secundarias en los hogares y otros factores sugieren que su infectividad ha aumentado en comparación con las cepas convencionales, y que por lo tanto las medidas de prevención siguen siendo cruciales.
Con respecto a la tecnología nanoe™, Panasonic verificó su efecto inhibidor sobre el nuevo coronavirus (SARS-CoV-2)*3 en julio de 2020 y su efecto inhibidor sobre cuatro nuevas variantes de coronavirus*4 en noviembre de 2021. Los resultados de las pruebas anteriores se realizaron en un espacio de prueba de 45 litros.
Por lo tanto, Panasonic llevó a cabo un experimento comparativo en un espacio de prueba de 24 m3 para comparar virus con y sin exposición a nanoe™. Un trozo de gasa saturada con la cepa Delta del nuevo coronavirus se expuso a nanoe™ durante 8 horas y se confirmó el efecto inhibidor de más del 99 %. (A tener en cuenta que los resultados de la verificación se basan en una prueba en un entorno de prueba cerrado y no en un espacio realmente en uso.)
Panasonic continuará impulsando el potencial de la tecnología nanoe™ y contribuirá a la sociedad proporcionando espacios más seguros y protegidos.
- Referencias:
Confirmación del efecto inhibidor de la tecnología nanoe sobre el nuevo coronavirus (SARS-CoV-2) adherido en un espacio de prueba de aproximadamente 24m3
- Descripción:
Se realizó una verificación comparativa en un espacio de prueba de 24m3 que contenía el nuevo coronavirus (SARS-CoV-2) adherido de la variante Delta
- Resultados:
La reducción de la infección por virus se establece en más del 99% contra la variante Delta del nuevo coronavirus adherido (SARS-CoV-2) con la tecnología nanoe™ se verificó en un espacio de prueba de 24 m3.
Nota: Esta verificación se diseñó para generar datos de investigación básicos sobre los efectos de nanoe™ en el nuevo coronavirus en condiciones de laboratorio diferentes de las que se encuentran en los espacios habitables.
- Datos de los resultados:

- Foto de la placa:
- Metodología y datos:
Organización: Centro de Calidad y Tecnología de Productos Textiles de Japón (QTEC)
Sujeto: Nueva variante Delta del coronavirus adherido (SARS-CoV-2)
Dispositivo: dispositivo nanoe™
Método:
► En un espacio de prueba de 24m3 (2700mm x 3640mm x 2450mm), se coloca un trozo de gasa saturada con la solución de virus en una distancia de 1,5m del generador nanoe™ y a 1,2m del suelo, y se expone a nanoe™ (dispersado en el espacio de prueba por el flujo de aire de un soplador instalado en la pared).*5

► La cuantificación de infección viral se mide y la tasa de inhibición*6 se calcula.
- Principio de la generación de radicales hidroxilo

El electrodo de atomización se enfría mediante un elemento Peltier, que condensa la humedad del aire para crear agua. Posteriormente, se aplica un alto voltaje a través de la atomización y los contraelectrodos para generar "radicales hidroxilo contenidos en el agua" de aprox. 5 a 20 nm de tamaño.
*1 Tecnología de partículas de agua atomizada electrostática de tamaño nanométrico
*2 Con respecto a la tecnología de limpieza de aire de tipo emisión de iones (al 1 de marzo de 2022, encuesta realizada por Panasonic)
*3 Verificación del efecto inhibidor de los radicales hidroxilo contenidos en el agua sobre el nuevo coronavirus (SARS-CoV-2) (Publicado en julio de 2020)
*4 Verificación del efecto inhibitorio de la tecnología nanoe sobre cuatro cepas mutantes del nuevo coronavirus (publicado en noviembre de 2021). El nuevo coronavirus y las cuatro cepas mutantes mostraron la misma tendencia decreciente independientemente de la cepa. Se pueden esperar los mismos resultados para las cepas mutantes que puedan surgir en el futuro si se prueban en las mismas condiciones en 45L.
*5 Basado en el "Método de prueba para evaluar el rendimiento de los purificadores de aire en la inhibición de virus que se adhieren en los espacios interiores (establecido el 4 de julio de 2011)" especificado por la Asociación de Fabricantes Eléctricos de Japón.
*6 Calculado por Panasonic.



Panasonic ha anunciado que la compañía, en colaboración con el Centro de Calidad y Tecnología de Productos Textiles de Japón